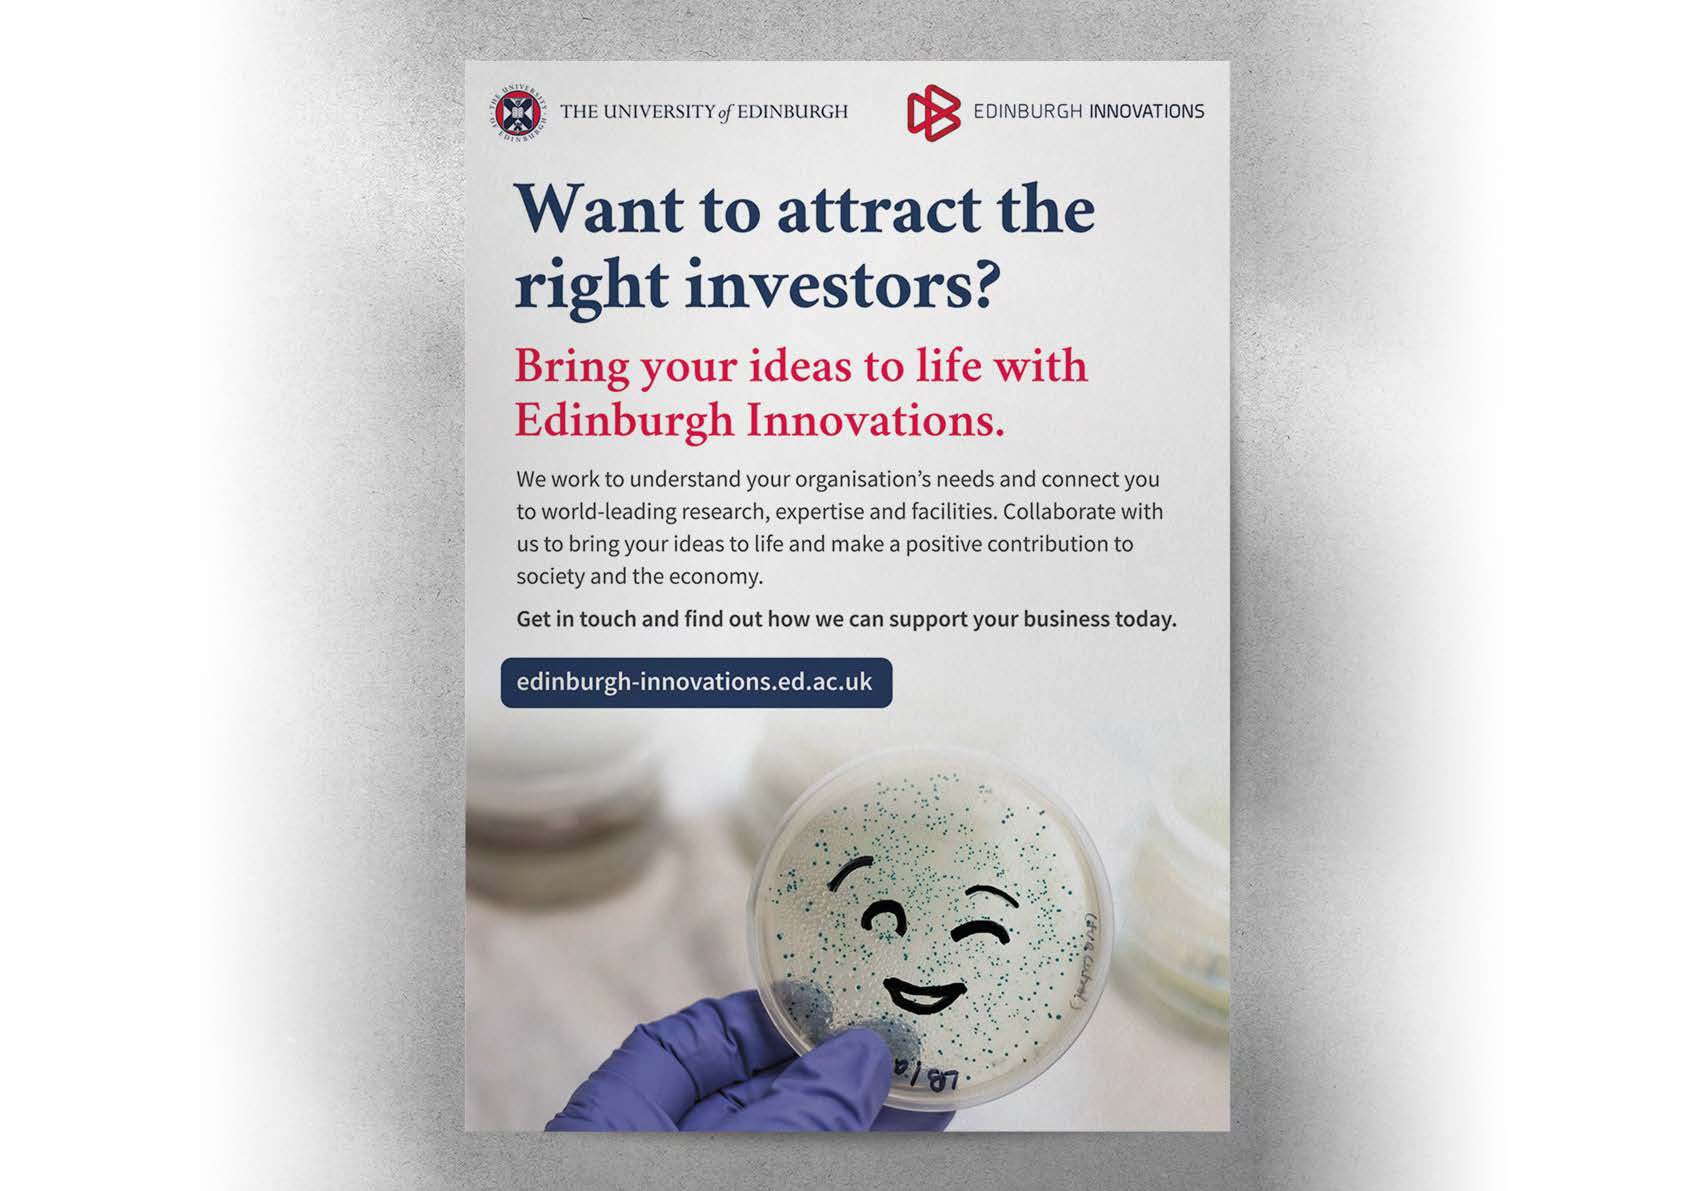

Enter the Dark Genome
I used A.I to generate an image of a double helix appearing through a door way. I then edited and expanded the canvas, enhancing the vibrancy of the image.


Pint of Science
Pint of Science is an event that takes place every year during the Edinburgh Fringe festival, where scientists talk about their research. I use their brand theme and colours to create social media graphics.




Science Insights
Science Insights is a work experience programme where S5 pupils get to work at various science labs across the UoE over the summer. Each year I create graphics to recruit participants on socials.




Edinburgh Innovations
Brief: Present concepts for a campaign aimed at CMVM researchers to raise awareness of the benefits of taking on commercial work with support from Edinburgh Innovations.
Concept: Bring your ideas to life (To make something very interesting, appealing or exciting).